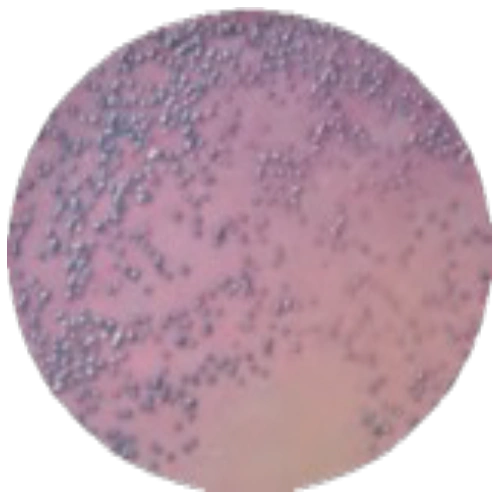

Хромогенная среда для выделения E.coli 0157:H7
Описание
Выделение и подсчет E.coli 0157:H7 на основе хромогенной дифференциации
Доступные артикулы:
MF019-20PT
MF019-50PT
MF019F-20PT
MF019F-50PT
Доступные артикулы:
MF019-20PT
MF019-50PT
MF019F-20PT
MF019F-50PT
Характеристики
Области применения
Вода, продукты питания
Документация
HiMedia Laboratories Pvt. Ltd. - абсолютный лидер по ассортименту поставляемых питательных сред.